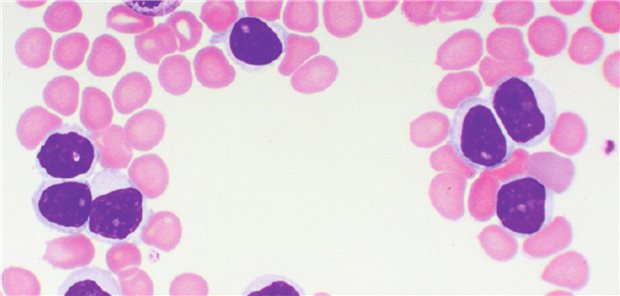
Acalabrutinib: TTNT-Update der AMPLIFY-Studie und RWE-Daten

Neue Onkologie-Spitzenzentren
Nachhaltiger Schub für die Krebsforschung
In Deutschland gibt es drei neue Comprehensive Cancer Center. Diese sollen der translationalen Forschung ebenso Auftrieb geben wie die Nationale Dekade gegen Krebs.
Veröffentlicht:
Die Onkologie ist ein stark forschungsgetriebener Versorgungsbereich.
© Scanrail / stock.adobe.com
Bonn/Berlin. Die Universitätskliniken Frankfurt am Main und Marburg, die Universitätsmedizin Göttingen sowie die Medizinische Hochschule Hannover und die Universitätskliniken Essen und Münster haben sich zu Onkologischen Spitzenzentren (Comprehensive Cancer Center) zusammengeschlossen, um für Betroffene in der jeweiligen Region die bestmögliche Krebsversorgung zu gewährleisten.
Die Deutsche Krebshilfe begrüßt diese Schritte als erhebliche Weiterentwicklung der Krebsmedizin und Patientenversorgung auf höchstem Niveau. „Mit diesen drei neuen Allianzen will die Deutsche Krebshilfe ihre vor fast 14 Jahren auf den Weg gebrachte Initiative der CCC fortentwickeln, die Versorgungsstrukturen weiter prägen und somit die Versorgung von Krebspatienten kontinuierlich verbessern“, verdeutlicht Gerd Nettekoven, Vorstandsvorsitzender der Deutschen Krebshilfe.
Die Organisation erhofft sich von den CCC explizit auch eine Stärkung der translationalen onkologischen Forschung in Deutschland. Die neuen Verbünde würden mit insgesamt 11,4 Millionen Euro für vier Jahre von der Deutschen Krebshilfe gefördert.
In den vergangenen Jahren hat die Deutsche Krebshilfe nach eigener Aussage mit ihrer CCC-Initiative die Grundlagen für eine flächendeckende, strukturierte, leistungsfähige und zukunftsorientierte Patientenversorgung geschaffen. CCC-Konsortien sieht sie als wichtige Meilensteine und konsequente Weiterentwicklung ihrer Bemühungen an.
Neue Forschungen angestoßen
Derweil zog Bundesforschungsministerin Anja Karliczek (CDU) anlässlich des Weltkrebstages am 4. Februar eine positive Zwischenbilanz zum zweijährigen Bestehen der Nationalen Dekade gegen Krebs. Vor zwei Jahren hat das Bundesministerium für Bildung und Forschung (BMBF) gemeinsam mit dem Bundesministerium für Gesundheit (BMG) und weiteren Partnern das Bündnis Nationale Dekade gegen Krebs initiiert.
Karliczek versicherte, Krebs sei Corona nicht zum Opfer gefallen: „COVID-19 und insbesondere die rasante und erfolgreiche Impfstoffentwicklung war das bestimmende Forschungsthema des vergangenen Jahres. Auch wenn über die Krebsforschung nicht soviel gesprochen wurde, ist die Bekämpfung des Krebses für unser Haus weiter ein prioritäres Vorhaben.“
Das BMBF habe beispielsweise neue Forschungen im Bereich der Darmkrebsprävention angestoßen. Konkret fördere es interdisziplinäre Verbünde zur Erforschung der Prävention von Darmkrebs bei jüngeren Menschen. „Wir wollen auch besser verstehen, was in Tumorzellen genau passiert, wie sie sich immer weiter vermehren und warum sie sich auch innerhalb eines Tumors unterscheiden können. Dazu fördern wir die Forschungen zur Tumorheterogenität und darauf basierenden neuen Behandlungsstrategien“, so Karliczek.
Engagement auch in Europa
Darüber hinaus investiere das BMBF neben den bisherigen Standorten in Heidelberg und Dresden in den Ausbau des Nationalen Centrums für Tumorerkrankungen an den vier potenziellen neuen Standorten Berlin, Essen/Köln, Stuttgart/Tübingen-Ulm und Würzburg mit den Partnern Erlangen, Regensburg, Augsburg. Damit könnten Patienten künftig schneller und wohnortnah von den Ergebnissen aus der Krebsforschung profitieren.
Karliczek erinnerte auch an ihr Engagement auf europäischer Ebene: „Wir wollen auch in Europa aktiv gegen den Krebs vorgehen. Gemeinsam mit Portugal und Slowenien haben wir im Rahmen der deutschen EU-Ratspräsidentschaft deshalb eine Deklaration zur Stärkung der europäischen Krebsforschung verabschiedet, um den Menschen überall in Europa den gleichen Zugang zur besten und modernsten Versorgung zu ermöglichen.“